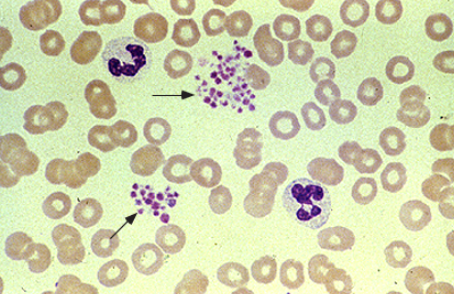

50대/남자
혈소판감소증 76 K로 내원하였습니다.
혈소판응집이 관찰된다고 이미 기술되어 있습니다.

Platelet clumping은 pseudothrombocytopenia 가능성을 시사합니다.
Unexpected thrombocytopenia 환자에서 필요한 검사는 complete blood count (CBC)와 peripheral blood smear를 시행합니다. 추가 평가를 하기 전에 가성혈소판감소증의 가능성 (즉, 혈소판 수가 잘못됨)을 제거해야 합니다. 가성혈소판감소증은 여러 상황에서 발생할 수 있으며, 말초혈액도말 검사 및/또는 non-EDTA anticoagulant를 사용하여 CBC를 반복하여 확인할 수 있습니다. 혈소판 응집이 관찰되면, collection tube에 있는 항응고제로 헤파린 또는 시트르산 나트륨을 사용하여 혈소판수를 다시 반복됩니다.

Pseudothrombocytopenia due to platelet clumping in EDTA
This peripheral blood smear shows platelet clumping (arrows) in an EDTA-anticoagulated blood sample. This patient had an EDTA-dependent platelet agglutinin that caused in vitro platelet clumping, resulting in an artifactually low platelet count (ie, "pseudothrombocytopenia"). No platelet clumping was seen, and the platelet count was normal, in a blood sample from this patient anticoagulated with sodium citrate.
CBC와 PBS : 정상입니다.





